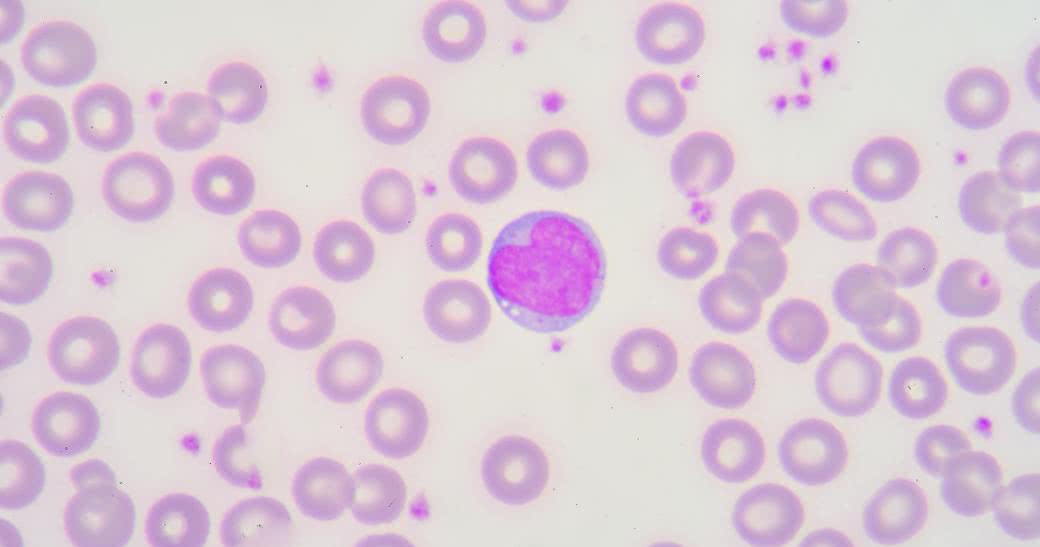

Limfocyty – co to takiego?
Limfocyty to rodzaj leukocytów (białych krwinek) odgrywających kluczową rolę w pracy układu odpornościowego. To właśnie limfocyty decydują o tym, jak ma przebiegać reakcja immunologiczna na drobnoustroje chorobotwórcze i inne obce substancje.
Limfocyty zarówno krążą po organizmie, jak i są zgromadzone w niektórych rejonach ciała, zwłaszcza w śledzionie, migdałkach i węzłach chłonnych, skąd uaktywniają się w ramach odpowiedzi immunologicznej.
Na powierzchni limfocytów znajdują się receptory antygenowe. Te białe krwinki przemieszczają się w kierunku innych komórek (i wirusów) i przy pomocy wspomnianych receptorów szukają antygenów, które znają1 . Można więc powiedzieć, że niczym książę z bajki poszukują swojego Kopciuszka – z tym tylko, że tutaj dopasowanie kończy się odpowiedzią immunologiczną i zniszczeniem rozpoznanego antygenu.
Nowo powstałe limfocyty, które nie miały jeszcze kontaktu z patogenami i nie wytworzyły receptorów antygenowych, nazywane są limfocytami dziewiczymi. To małe komórki o średnicy 8-10 μm. Kiedy zostaną wystawione na kontakt z patogenami, rozrastają się i specjalizują2 . Poszczególne grupy limfocytów są więc w stanie rozpoznać konkretne patogeny, dlatego też cała populacja może zapobiegać w tym samym czasie wielu zagrożeniom.
Limfocyty – rodzaje komórek
Limfocyty dzielą się na 2 podstawowe typy: B i T. Wszystkie powstają w wyniku różnicowania się komórek macierzystych szpiku kostnego i na początku wyglądają podobnie. Niektóre limfocyty migrują do grasicy (gruczoł w klatce piersiowej w okolicach mostka), gdzie dojrzewają limfocyty T (od łac. thymus, czyli grasica), inne natomiast pozostają w szpiku kostnym, gdzie rozwijają się w limfocyty B1 (od łac. bursa Fabricii, czyli torebka Fabrycjusza – narząd limfatyczny występujący u ptaków o funkcjach zbliżonych do grasicy).
Rola limfocytów w organizmie
Większość limfocytów żyje zaledwie kilka dni do kilku miesięcy, niektóre z nich mogą jednak przeżyć latami. Stanowią one element pamięci immunologicznej – pod tym terminem kryje się szybka odpowiedź w razie drugiego spotkania z tym samym antygenem.
W ramach odpowiedzi immunologicznej niektóre limfocyty B różnicują się w komórki osocza, które wytwarzają przeciwciała. Ich zadaniem jest znaleźć niepożądany antygen i rozpocząć jego neutralizację lub destrukcję – w praktyce oznacza to zniszczenie wirusa lub bakterii, która posiada ów antygen.
Produkcja przeciwciał utrzymuje się aż do ich całkowitej eliminacji (może to trwać nawet kilka miesięcy). W tym czasie inne limfocyty B, zwane komórkami pamięciowymi, namnażają się, a ich celem jest przechowywanie w "długotrwałej pamięci” układu odpornościowego informacji o groźnych antygenach.
Natomiast limfocyty T namnażają się i różnicują w grasicy na komórki pomocnicze, regulatory i komórki cytotoksyczne; mogą też stać się (podobnie jak limfocyty B) komórkami pamięci immunologicznej. Tak przygotowane limfocyty T kierują się ku tkankom; niektóre wchodzą też w skład krwi i limfy. Kiedy rozpoznają wrogi antygen, następuje szereg reakcji biochemicznych. Wybrane limfocyty T reagują na rozpoznane antygeny w następujący sposób:
- limfocyty Th (komórki pomocnicze) uwalniają cytokiny, chemiczne przekaźniki, które stymulują proces różnicowania limfocytów B w komórki osocza,
- limfocyty Treg (regulatory) przejmują kontrolę nad reakcjami immunologicznymi,
- limfocyty T cytotoksyczne, wiążą się z zainfekowanymi komórkami oraz komórkami rakowymi i niszczą je1 (stąd inna ich nazwa: komórki NK, czyli z ang. natural killer cells).
Jak badać limfocyty?
Wartości limfocytów uwzględnia się podczas standardowego badania krwi (morfologii). Nie trzeba więc zastanawiać się, jakie badanie na limfocyty należy wykonać, ponieważ wszystkie składniki krwi są mierzone podczas morfologii.
Norma w przypadku dorosłych oznacza 1,000-4,800 limfocytów w 1 μl (mikrolitr) krwi.
W przypadku dzieci za prawidłową liczbę limfocytów uważa się 3,000-9,500 komórek w 1μl krwi. U zdrowego dorosłego limfocyty stanowią ok. 20-40% wszystkich białych krwinek1 . A zatem limfocyty stanowiące np. 47% białych krwinek nie mieszczą się w granicach normy.
Zwykle podwyższony poziom limfocytów świadczy o tym, że organizm toczy choroba. Może to być niemal wszystko – od przeziębienia po silne stany zapalne i alergie, ponieważ źle ukierunkowane limfocyty reagują na antygeny (białka) pokarmowe i wszczynają alarm w organizmie. Jeśli jednak limfocyty są dużo poniżej lub powyżej normy, należy niezwłocznie zgłosić się do lekarza.
Podwyższone limfocyty – przyczyny
Wysokie stężenie limfocytów może świadczyć o chorobie układu odpornościowego, krwionośnego bądź limfatycznego. Do schorzeń z podwyższonym poziomem limfocytów należą:
- ostra białaczka limfocytowa (najczęstszy typ raka u dzieci, z dobrym rokowaniem; jeśli jednak rozwinie się u dorosłej osoby, o wiele trudniej go wyleczyć)3 ,
- przewlekła białaczka limfocytowa (choroba atakująca najczęściej osoby starsze)4 ,
- infekcja cytomegalowirusem (zakażenie groźne dla kobiet ciężarnych i karmiących piersią, ponieważ przekracza barierę krew-łożysko oraz przenika do mleka powodując zmiany u płodu i dziecka)5 ,
- wirusowe zapalenie wątroby typu A (uszkadzająca wątrobę choroba przenoszona przez bliski kontakt z zakażoną osobą, ale też zakażony pokarm i wodę)6 ,
- wirusowe zapalenie wątroby typu B (schorzenie mogące prowadzić do niewydolności wątroby, marskości lub nowotworu tego organu)7 ,
- wirusowe zapalenie wątroby typu C (infekcja przenosząca się przez zakażoną krew, o przebiegu pozbawionym niekiedy widocznych objawów)8 ,
- chłoniak (ogólna nazwa na nowotwory atakujące układ limfatyczny, w tym węzły chłonne i/lub śledzionę)9 ,
- mononukleoza (zakażenie wirusem Epsteina-Barr przenoszące się np. przez pocałunek lub korzystanie z tych samych naczyń podczas posiłku)10 .
Inne zaburzenia dotyczące wysokiego poziomu limfocytów mogą obejmować kiłę, krztusiec, niedoczynność tarczycy i reakcję na niektóre leki. Niekiedy też przewlekły stres objawia się między innymi podniesionym poziomem limfocytów11 .
Obniżone limfocyty – przyczyny
Tzw. wysokie limfocyty to nie jedyna możliwa anomalia związana z tymi białymi krwinkami. Zbyt niski poziom limfocytów również może świadczyć o poważnych problemach zdrowotnych. Wśród nich można wymienić:
- niektóre nowotwory z grupy białaczek,
- niektóre zakażenia wirusowe oraz ciężkie infekcje, których zwalczanie pochłania więcej limfocytów niż organizm jest w stanie w danym czasie wytworzyć,
- wrodzone zaburzenia funkcji szpiku kostnego,
- niektóre leki, w tym antybiotyki, które niszczą białe krwinki,
- sarkoidoza (choroba układowa atakująca najczęściej węzły chłonne i płuca).
Inne możliwe przyczyny małej liczby limfocytów to anemia, zaburzenia pracy śledziony, toczeń i zespoły mielodysplastyczne (zaburzenia budowy i funkcji komórek krwi), a także terapie nowotworowe: chemio- i radioterapia. Również niedobory składników odżywczych wpływają negatywnie na liczbę limfocytów12 .
Warto przy tym zauważyć, że niektóre schorzenia mogą objawiać się zarówno zbyt wysokim, jak i zbyt niskim poziomem limfocytów. Są to między innymi: zakażenie HIV / rozwój AIDS, gruźlica, choroby o podłożu autoimmunologicznym11,12 . Dlatego też jakiekolwiek odstępstwa od normy w liczbie tych białych krwinek powinny być wskazaniem do zasięgnięcia opinii lekarza.
Jednocześnie należy pamiętać, że jedynie lekarz może interpretować wyniki badania krwi, ponieważ – jak już wspomniano – na różnych etapach życia inna liczba białych krwinek jest uważana za normę.
- https://www.britannica.com/science/lymphocyte
- Tuberculosis, A Comprehensive Clinical Reference 2009, Pages 117-128
- https://www.mayoclinic.org/diseases-conditions/acute-lymphocytic-leukemia/symptoms-causes/syc- 20369077
- https://www.mayoclinic.org/diseases-conditions/chronic-lymphocytic-leukemia/symptoms-causes/syc- 20352428
- https://www.mayoclinic.org/diseases-conditions/cmv/symptoms-causes/syc-20355358
- https://www.mayoclinic.org/diseases-conditions/hepatitis-a/symptoms-causes/syc-20367007
- https://www.mayoclinic.org/diseases-conditions/hepatitis-b/symptoms-causes/syc-20366802
- https://www.mayoclinic.org/diseases-conditions/hepatitis-c/symptoms-causes/syc-20354278
- https://www.mayoclinic.org/diseases-conditions/lymphoma/symptoms-causes/syc-20352638
- https://www.mayoclinic.org/diseases-conditions/mononucleosis/symptoms-causes/syc-20350328
- https://www.mayoclinic.org/symptoms/lymphocytosis/basics/causes/sym-20050660
- https://www.mayoclinic.org/diseases-conditions/myelodysplastic-syndrome/symptoms-causes/syc- 20366977

 Nasze magazyny
Nasze magazyny